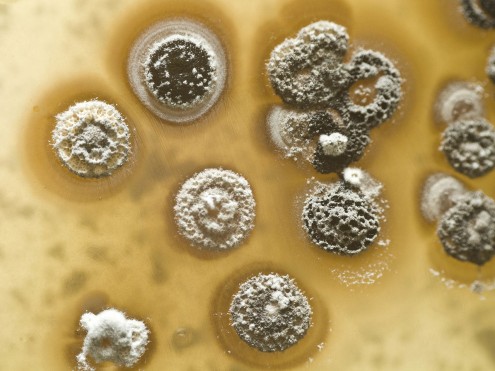
streptomyces galaxy

From Shengcha to Shu Cha, a Microbial Change
Shengcha pu’er looks and tastes differently from its dark colour cousin, shu cha pu’er. Yet it is also called a pu’er. Although it is a normal product nowadays, throughout antiquity, it had always been sold as the material for producing dark tea1.
We have categorised shengcha as a lightly oxidised tea2, in the same category as white tea, and yet all collectors of high price shengcha would want the tea turn dark gracefully to excel in quality. That means they expect a shengcha to become a dark tea, in the same category as shu cha, and as people in antiquity had understood the tea.
Let’s go beyond labelling and look at the nature of this “darkening” process and what determines a good pu’er.
- A shengcha puer tea from the famous origin Bulang Shan in Xishuangbana in southern Yunnan
- Mengku Shengcha Pu’er 勐庫生茶普洱, aged dark tea
- Yiwu Daye, Matured Shengcha Pu’er 陳年易武大葉生茶普洱
- Daye Pu’er, baked 焙火大葉普洱
- Imperial Golden Tip Pu’er, aka Golden Tip Pu’er, or Gong-ting Pu’er 宮廷普洱 is a tippy fine leaf post-fermented dark tea. This one from 1997.
It’s a Mouldy business
Whether it is induced post-fermentation ( aka oudui — 漚堆 ) in modern dark tea processing, or “natural” post-fermentation as in the ancient process, the darkening of pu’er is complex. Its nature is yet to be thoroughly understood in scientific terms. However, it has always been clear that microbial activities are critical contribution to the final bio-chemical character. These microbes are largely common fungal organisms.
A group of scientists in Taiwan tried to find out what it is in top quality pu’er that render its good tastes and health effects. They gathered some of the best products, including some extremely expensive and most sought after traditional renowned shengcha matured for 25 years, to analyse their constituents. Basing on the study, they tried to replicate the best pu’er in the lab and made some ground breaking finds.3
A macroscopic photo of streptomyces — some strains are known as common mould — grown in a lab. Such bioactivities happen in much less visible scale in the darkening of pu’er, be it shengcha or shu cha. However, if you see your final product having that with your naked eyes, it means your tea has not been properly processed, handled, packaged or stored. Certain people in the trade give beautiful names to evidences of such malpractices. Silver flower, gold flower etc are hoaxes. They are either parroting, cheating, or trying to convince themselves that their fouled product is superior.
54 strains of moulds and bacteria were identified in the matured pu’er teas. They took these 54 different microbes each to ferment a batch of freshly picked tealeaves, thereby making 54 pu’er teas each from one particular strand of microbe. In another word, they executed for the first time in history 54 different pu’er dark teas with precisely selected versions of microbes. They analyzed the products and let the tasters taste them. They concluded that 15 of the microbes were related to good taste and health contributing contents.
42 days of Fermentation vs 25 years of Maturing
The catch is, they have fermented these leaves for only 42 days, and their health content and health capabilities either match or exceed the expensive 20~25 years matured premium grade pu’er cha bings many times. As for the tasting scores, although the Taiwan scientists have not published it, I am sure that they have some competitive data of the lab-made teas over the expensive teas. That is because in most cases of other tea categories, quantity of health elements is closely related with taste4.
The scientists measured a few health contributive indicators, such as the content for statin, GABA, polyphenols, radical scavenging activities etc and concluded that the lab fermented teas increased a few times than those of the fresh tealeaves. What they didn’t say was that they are also either as good as or, in some aspects, many times over that of the expensive teas. We have used their figures to make these graphs to illustrate the point.

Tea polyphenols content, at 42 days of post fermentation by various strains of microbes
unit= mg/g dw
The microbes were code-named by a simple number referring to which premium pu’er the scientists extract them from. The control data is detected from the same fresh tealeaves that the scientists used to produce the lab pu’ers. Note that some of the strains, notably Y11 and R9, produce polyphenols that amount to over 3 times that of the fresh leaves.
Actual production pu’ers should vary, since the fresh leaves here, detected to have 10 mg/g of polyphenols, seems to be of a low polyphenol cultivar and are very much grown leaves. Normally most other cultivars picked at or near the tip should have a dry weight content of 18~33 mg/g. It is likely that the Taiwanese scientists followed a secret rule in higher price pu’er production — to pick larger leaves and/or later seasons for the study. It is widely believed in the trade that such picks for higher price pu’er teas render superior tastes. Click here to read more about polyphenol content in pluck position
Health Effects of Pu’er Tea
Although many more studies are needed to confirm its salutary effectiveness, drinking of pu’er has been proven to reduce LDL ( low-density lipoprotein, i.e. bad cholesterols ) levels. Lowering of LDL is also a means of preventing cardiovascular diseases. It could have been the effect of the high level of polyphenols, or some contribution from the naturally occurring statin in pu’er.
In some other studies, scientists discovered a polyphenol matter unidentified elsewhere but only in pu’er tea. They name it puerrin. It is one of the major constituents in the polyphenols amount in pu’er 5, which has found to have increased dramatically during post-fermentation by the Taiwan scientists. The way puerrin function in the human body has yet to be further studied.

Statin content comparison between matured premium shengcha puer products and lab made pu’ers
Unit = ng/g dw
The lab made puers are code-named with the particular strains of microbes each from the 3 pu’ers on the top of the list. We do not want to disclose publicly the names of these 3 teas involved since they are extremely high price collector items. The initial Y denotes a strain of microbe from an original shengcha that has darkened through aging. R for that from a shengcha-shu-cha blend. It is also important to note that normally the post-fermentation for pu’ers last for about 60~90 days instead of 42.
Another group of scientists consider theabrownins, the same group of materials in aged black tea and exists in minute quantities in other teas may be the cause. Again, much study is needed for theabrownin.
Practicality ( or rather indolence ) of everyday use
In the Taiwan study they also found high capabilities of the lab teas in radical scavenging, i.e. anti-oxdative activities. This is in agreements with the results of a few other studies on the cancer prevention of pu’er tea.
Besides scientific findings, the one most important health benefits of pu’er is its mild and easy character (shu cha, or well-darkened shengcha) when steeped at moderate strength, so one has a dark yet mild enough drink at any time of the day all day long without the need of milk or sugar. The tea stands well to abusive or careless infusion practices, can be diluted when too strong and can be left in the pot for the day with hot water and still holding on a consistent taste profile. A tea tolerating as such spoils its drinker for inattentiveness. This way anyone can be drinking the whole day a fine drink while enjoying tea’s general health benefits.
That is not to say, however, care and skills are not needed for the perfect cup of pu’er.
Between Shengcha and Shu Cha
What the scientists did in the lab may not be popularly employed by pu’er producers yet, but proper post-fermentation has always been geared towards attracting the growth of the desired microbes. The tea merchants who invented the process might not be aware of the health benefits this “darkening” process brings to the tea, but the lab tea data have proven this is a great process for improving the taste and health values of this taken for granted drink.
Finer shengcha has its appeal with a taste profile of a much wider gamut, and its property would not be the same through its various stages of darkening. According to this Taiwan study, however, their matured versions do not provide as much health giving potential.
Fresher shengcha, however, should be understood as a white tea. Not only does it taste entirely differently but also its health implications should also be understood as that of white teas For those who are more aware of TCM nature of tea, a fresher shengcha is either cold or cool in its TCM character, depending of finish processing and year and conditions of storage.
Production Processing for the Darkening of Pu’er tea will Change
The Taiwan study made such a great impact in the world of pu’er that subsequent studies were made. A few factories have even set up high-tech post-fermentation processing with isolated strains of microbes, aiming to replicate high value productions without the guess-work, influence of ambient conditions and highly specialised labours.
We are still expecting satisfactory samples to come through our mail some day.
- A number of articles in this site discuss this topic. Please begin with Dark Tea: From Crude Provision to Treasure ↩
- For more reference please read Shengcha ↩
- KC Jeng et al, Effect of Microbial Fermentation on Content of Statin, GABA, and Polyphenols in Pu-Erh Tea, Journal of Agricultural and Food Chemistry 2007, 55, 8787–8792 ↩
- For more references on this subject please read Polyphenol Content: Not All Teas are Created Equal ↩
- HT Zhu et al, Advances on the Research of Microbes during the Post-fermentative Process of Pu-Er Tea, Acta Botanica Yunnanica, 2008, 30 (6): 718~724 ↩






